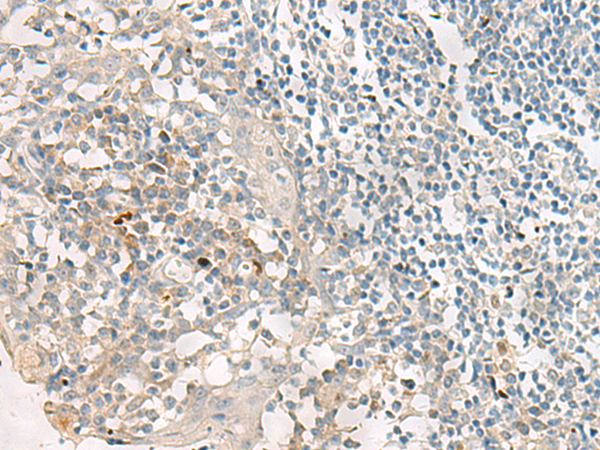

中文名稱 : 兔抗PROKR2多克隆抗體
英文名稱 : Anti-PROKR2 rabbit polyclonal antibody
別 名 : prokineticin receptor 2; HH3; KAL3; PKR2; GPRg2; GPR73b; GPR73L1; dJ680N4.3
儲 存 : 冷凍(-20℃)
抗 原 : PROKR2
宿 主 : Rabbit
反應(yīng)種屬 : Human
相關(guān)類別 : 一抗
標(biāo) 記 物 : Unconjugate
克隆類型 : rabbit polyclonal
技術(shù)規(guī)格
|
Background: |
Prokineticins are secreted proteins that can promote angiogenesis and induce strong gastrointestinal smooth muscle contraction. The protein encoded by this gene is an integral membrane protein and G protein-coupled receptor for prokineticins. The encoded protein is similar in sequence to GPR73, another G protein-coupled receptor for prokineticins. |
|
Applications: |
ELISA, IHC |
|
Name of antibody: |
PROKR2 |
|
Immunogen: |
Synthetic peptide of human PROKR2 |
|
Full name: |
prokineticin receptor 2 |
|
Synonyms: |
HH3; KAL3; PKR2; GPRg2; GPR73b; GPR73L1; dJ680N4.3 |
|
SwissProt: |
Q8NFJ6 |
|
ELISA Recommended dilution: |
5000-10000 |
|
IHC positive control: |
Human tonsil |
|
IHC Recommend dilution: |
10-50 |
購物車
購物車 幫助
幫助
 021-54845833/15800441009
021-54845833/15800441009
